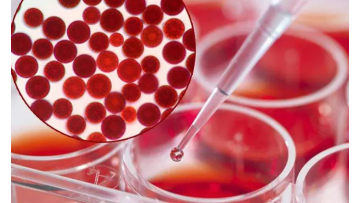

- Videos
- About us
Contact Supplier
Tell us your buying requirements-

-

Jinan Forever Chemical Co., Ltd.
5 Videos
-

Shenzhen Anheda Plastic Products Co.,Ltd
178 Videos
-

-

WONDER COATING TECHNOLOGY CO., LTD.
51 Videos
-

Liaoning Kelong Fine Chemical Co.Ltd.
22 Videos
-

Jiangsu Maoheng Chemical Co.,LTD
17 Videos
-

-

Henan Chuange Industry CO.,LTD
169 Videos
-

CAS Applied Chemistry Materials Co.,Ltd.
99 Videos
-

WUHAN RUISUNNY CHEMICAL CO. LTD
60 Videos
-

Wuxi Volksky New Materials Co.,Ltd.
323 Videos
Contact Supplier
Tell us your buying requirements-

-

Jinan Forever Chemical Co., Ltd.
5 Videos
-

Shenzhen Anheda Plastic Products Co.,Ltd
178 Videos
-

-

WONDER COATING TECHNOLOGY CO., LTD.
51 Videos
-

Liaoning Kelong Fine Chemical Co.Ltd.
22 Videos
-

Jiangsu Maoheng Chemical Co.,LTD
17 Videos
-

-

Henan Chuange Industry CO.,LTD
169 Videos
-

CAS Applied Chemistry Materials Co.,Ltd.
99 Videos
-

WUHAN RUISUNNY CHEMICAL CO. LTD
60 Videos
-

Wuxi Volksky New Materials Co.,Ltd.
323 Videos

The user has not added any information yet
Company Info
- Business Type :
- Manufacturer , Trade Company
- Product Range :
- Herbal Medicine
- Products/Service :
- Food Raw Materials, Cosmetic raw materials, Food Raw Materials, Plant Extract , Vegetable Powder, Fruit powder
- Total Employees :
- > 5~50
- Capital (Million USS) :
- 500000RMB
- Year Established :
- 2018
- Certificate :
- GS , ISO9001 , FSC , TUV , UL
- Company Address :
- Xian, Shaanxi, China
If you are interested in the product, contact Bossgoovideo.com for more information
- *To:
- Xi'an complex bio-tech CO.,LTD.
- *Message:
-
Submit